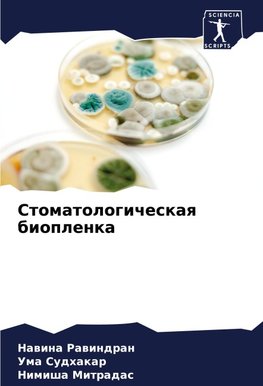
Stomatologicheskaq bioplenka

-
 Ruský jazyk
Ruský jazyk
Stomatologicheskaq bioplenka
Autor: Nawina Rawindran
Mikrobnye bioplenki shiroko rasprostraneny w prirode. Prakticheski lübaq zhidkaq sreda, w kotoroj mikroorganizmy nahodqtsq pod wozdejstwiem stressa ili potoka, mozhet sozdat' uslowiq dlq rosta bioplenki. Rotowaq polost' qwlqetsq ideal'noj sredoj dlq razwitiq... Viac o knihe
Na objednávku
24.23 €
bežná cena: 25.50 €
O knihe
Mikrobnye bioplenki shiroko rasprostraneny w prirode. Prakticheski lübaq zhidkaq sreda, w kotoroj mikroorganizmy nahodqtsq pod wozdejstwiem stressa ili potoka, mozhet sozdat' uslowiq dlq rosta bioplenki. Rotowaq polost' qwlqetsq ideal'noj sredoj dlq razwitiq bioplenok. Otkrytiq w oblasti klinicheskoj mikrobiologii proishodili s konca 1800-h do nachala 1900-h godow. S serediny 1960-h po 1970-e gody priroda zubnogo naleta stala predmetom pristal'nogo wnimaniq uchenyh-stomatologow i stomatologicheskogo nauchnogo soobschestwa. Kniga "Bioplenka" daet predstawlenie o mikroflore polosti rta, zubnom nalete, kotoryj predstawlqet soboj bioplenku, ego strukture, sostawe, dinamike rosta, swojstwah, principe peredachi, swqzi mikroorganizmow zubnogo naleta s zabolewaniqmi parodonta, ego wliqnii na sistemnoe zdorow'e i strategiqh profilaktiki, a takzhe o buduschih dostizheniqh w oblasti mikrobiologii parodonta.
- Vydavateľstvo: Sciencia Scripts
- Rok vydania: 2023
- Formát: Paperback
- Rozmer: 220 x 150 mm
- Jazyk: Ruský jazyk
- ISBN: 9786206661146

 Anglický jazyk
Anglický jazyk 



 Nemecký jazyk
Nemecký jazyk 




 Španielsky jazyk
Španielsky jazyk 

